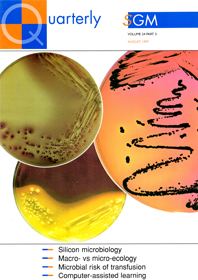
Cover of Microbiology Today, issue of August 1997

Past issues
Microbiology Today began in 1999; previous to this the Society magazine was called SGM Quarterly. For details of issues published before 1998, please contact the Editorial Office.
- Order by:
- Date
- A-Z
-
Actinobacteria
May 2007
The May 2007 issue of Microbiology Today focuses on actinobacteria.
-
Alternative sources
November 1998
The November 1998 issue of SGM Quarterly focuses on alternative sources for a variety of things such as antimicrobial drugs and tissue donors.
-
Antimicrobials
November 2012
The November 2012 issue of Microbiology Today contains a variety of articles on antimicrobials.
-
Antimicrobials - where next?
May 2004
The May 2004 issue of Microbiology Today focuses on the future of antimicrobials.
-
Arboviruses and their Vectors
August 2019
Microbiology Today August 2019 considers some of the viruses that are transmitted by arthropods and the arthropod vectors that carry them. The five feature articles look at how arboviruses affect plants, animals and humans alike and cover a range of topics, from overviews of specific arboviruses to how to control the spread of the diseases they cause by targeting the vectors that facilitate their transmission.
-
Archaea
August 2017
From extreme temperatures and highly acidic conditions to the insides of volcanoes and the depths of the ocean, a diverse group of microbes called archaea thrive in many places that most life can't survive. This August issue of Microbiology Today highlights the importance of archaea and our current understanding of them.
-
Biodeterioration
August 2003
The August 2003 issue of Microbiology Today focuses on biodeterioration and biodegradation. Microbes can break down a great range of materials and often their action is unwanted, unsightly and uneconomic.
-
Biofuels
November 2013
The November 2013 issue of Microbiology Today focuses on biofuels.
-
Biogeography
August 2013
The August 2013 issue of Microbiology Today contains topical articles on biogeography.
-
Biophysics
May 1999
The May 1999 issue of Microbiology Today focuses on biophysics and the applications that are relevant to microbiology. It includes in-depth articles on Raman spectroscopy, Cryo-EM, imaging, NMR, X-ray crystallography and atomic force microscopy.
-
Bugs Get Everywhere
May 2008
The May 2008 issue of Microbiology Today focuses on the different and unusual places where microbes exist.
-
Bugs On Bugs
November 2008
The November 2008 issue of Microbiology Today focuses on small organisms being affected by even smaller organisms.
-
Can microbes feed the world? - RHS Chelsea Flower Show Issue
May 2012
This May 2012 issue of Microbiology Today is on the RHS Chelsea Flower Show.
-
Clinical Microbiology
February 2001
The February 2001 issue of Microbiology Today focuses on food microbiology. The importance of modern molecular techniques in advancing our knowledge of pathogens and how they work is emphasised in several articles.
-
Cytokines
November 2007
The November 2007 issue of Microbiology Today focuses on cytokines and interferons.
-
Darwin 200
May 2009
The May 2009 issue of Microbiology Today focuses on Charles Darwin and the evolution of microbes.
-
DNA 50
February 2003
The February 2003 issue of Microbiology Today focuses on the wonderful world of DNA. In this special issue we commemorate the 50th anniversary of the publication of the structure of DNA by James Watson and Francis Crick in Nature in 1953.
-
Emergent & resurgent pathogens
February 2011
The February 2011 issue of Microbiology Today focuses on new pathogens as well as re-emerging ones.
-
Emerging Opportunities
October 2024
The October 2024 edition of Microbiology Today is titled 'Emerging Opportunities.' This issue explores the use of bacteria to redefine our life on Earth and the role of microbes in space exploration. This issue looks at the opportunities microbiology provides for all of us.
-
Emerging Threats
May 2024
The May 2024 edition of Microbiology Today is titled 'Emerging Threats'. This issue explores threats from climate change to artificial intelligence, this issue explores a wide range of threats that microbiologists and the wider community face.
-
Engaging Microbiology
May 2022
The May 2022 edition of Microbiology Today is titled 'Engaging Microbiology'. This issue highlights the importance of teaching and outreach in championing and advancing the understanding of microbiology.
-
Escherichia coli
August 2004
The August 2004 issue of Microbiology Today focuses on the much maligned E. coli.
-
Eukaryotic microbes
August 2002
The August 2002 issue of Microbiology Today focuses on the study of eukaryotic microbiology.
-
Fighting microbes
February 1998
The February 1998 issue of SGM Quarterly focuses on two centenaries: the discovery of the Golgi apparatus and the pioneering work on Tobacco Mosaic Virus, as well as the topical subject of meningitis.
-
Fleming Prize Winners
October 2020
In this special anniversary edition of Microbiology Today, we are placing the spotlight on previous Fleming Prize winners to demonstrate why Microbiologists matter. Through a series of interviews, the winners share their career experiences and provide their personal take on the importance of microbiology.
-
Food
August 2010
The August 2010 issue of Microbiology Today focuses on microbes involved in and affecting food.
-
Food and Water
August 2007
The August 2007 issue of Microbiology Today focuses on the effects of microbes on the life sources, food and water.
-
Food Microbiology
February 2002
The February 2002 issue of Microbiology Today focuses on food microbiology. You are what you eat, and as most foods are closely associated with microbes in some way, either in their production, spoilage or as vehicles of disease, food microbiology is highly relevant to all our lives.
-
Fungal diseases
February 2016
Welcome to the February 2016 issue of Microbiology Today, which focuses on fungal diseases, covering Candida, ash dieback and Aspergillus.
-
Fungi
August 2000
The August 2000 issue of Microbiology Today focuses on fungi.
-
Future Tech
August 2016
Microbiologists and microbes are at the forefront of new invention and innovation, and the August issue of Microbiology Today focuses on 'Future Tech' – the pioneering work taking place in the field.
-
Genomics
November 1999
The November 1999 issue of Microbiology Today focuses on genomics, a very hot topic that offers exciting potential for solving microbiological problems in the next thousand years. Microbial sequencing is proceeding space, with new genomes being announced almost monthly. Analysing the resultant wealth of information is down to bioinformaticists. In a range of articles, geneticists and computer experts describe the techniques and applications of microbial genomics and explore some of the exciting future opportunities that this knowledge will bring.
-
GM plants
February 1999
The February 1999 issue of Microbiology Today focuses on the genetic modification of plants. Can we afford to ignore the new opportunities offered by genetically modified plants? Some of the issues surrounding this controversial issue are discussed.
-
Halting Epidemics
February 2017
Disease outbreaks need to be closely monitored and contained to limit their potential spread. The February 2017 issue of Microbiology Today focuses on epidemics and the measures taken to prevent the spread of disease.
-
Harry Smith Memorial Issue
August 2012
This August 2012 issue of Microbiology Today pays tribute to Past President, Harry Smith.
-
History and Miscellany
May 2006
The May 2006 issue of Microbiology Today focuses on the history of microbiology.
-
HIV and AIDS
November 2018
The November issue of Microbiology Today explores the various topics surrounding HIV and AIDS. The five feature articles look at the different ways in which HIV and AIDS affect people around the world today, examining the individual stories of those suffering from the disease, diagnosis, associated infections and how conditions such as pregnancy can affect those that are HIV-positive.
-
Honeybee
November 2011
This November 2011 issue of Microbiology Today focuses on the microbiological importance of the honeybee.
-
Imaging
February 2018
This issue of Microbiology Today focuses on the variety of ways that humans have been able to view micro-organisms, including some of the cutting edge methods of showing microbes in closer, and higher quality, detail than ever before.
-
Industrial Microbiology
May 2023
The May 2023 edition of Microbiology Today is titled 'Industrial Microbiology'. This issue explores the fascinating world of industrial microbiology, from career advice on how to break into the field to insights into how industry is using micro-organisms to solve global challenges.
-
Knocking Out AMR
October 2023
The October 2023 edition of Microbiology Today is titled 'Knocking Out AMR'. This issue explores some of the challenges and most recent advancements within antimicrobial resistance (AMR) research.
-
Life on a Changing Planet
May 2021
The May edition of Microbiology Today is titled 'Life on a Changing Planet'. Through each of our featured articles, the authors explore the chronic changes that have been inflicted on Earth's climate and how the microbial world has adapted, been impacted and how microbes could potentially offer solutions.
-
Life On Us
February 2008
The February 2008 issue of Microbiology Today focuses on microbes that live on or in the human body.
-
Life's A Gas
August 2008
The August 2008 issue of Microbiology Today focuses on gaseous microbial interactions.
-
Light
August 2015
Welcome to the August 2015 issue of Microbiology Today, which includes articles on the importance of light and microbiology.
-
Making Money From Microbes
February 2004
The February 2004 issue of Microbiology Today focuses on the lucrativeness of microbes.
-
Marine microbiology
November 2002
The November 2002 issue of Microbiology Today focuses on marine microbiology.
-
Metabolism, Health and Disease
May 2019
The May issue of Microbiology Today focuses on the varied interactions between humans and micro-organisms in terms of metabolism, health and disease. This issue's feature articles focus on a range of microbes, including bacteria, viruses and fungi, looking at both the beneficial impact on human health and how they cause disease.
-
Microbes and Cancer
August 2005
The August 2005 issue of Microbiology Today focuses on how microbes can be both the cause and cure of cancer.
-
Microbes and companion animals
November 2009
The November 2009 issue of Microbiology Today focuses on microbes that affect companion animals.
-
Microbes and Food
August 2018
The August 2018 issue of Microbiology Today focuses on the use of microbes and the roles they can play in food.
-
Microbes and Sex
May 2003
The May 2003 issue of Microbiology Today focuses on the interactions between micro-organisms and sex.
-
Microbes and the Human Body
November 2001
The November 2001 issue of Microbiology Today focuses on the human body. From the cradle to the grave, the human body interacts closely with micro-organisms. In this issue of your award-winning magazine we explore some of the relationships encountered at different stages in our lives.
-
Microbes at Work
May 2002
The May 2002 issue of Microbiology Today focuses on how the great diversity and adaptability of microbes can be exploited to our benefit by scientists.
-
Microbes in sport
August 2009
The August 2009 issue of Microbiology Today focuses on microbes in sport.
-
Microbes in the Air
November 2005
The November 2005 issue of Microbiology Today focuses on microbes in the air.
-
Microbes in the Garden
May 2005
The May 2005 issue of Microbiology Today focuses on microbes a little closer to home.
-
Microbes in the home
May 2000
The May 2000 issue of Microbiology Today focuses on microbes found in the home. Microbes are all around us, most of them harmless, but what can we do to protect ourselves from pathogens that might threaten us in the home?
-
Microbes Shaping History
February 2007
The February 2007 issue of Microbiology Today focuses on microbes that have shaped history.
-
Microbial Communities
February 2005
The February 2005 issue of Microbiology Today focuses on microbial communities.
-
Microbial communities: big society on a small scale
November 2010
The articles in this November 2010 issue of Microbiology Today look at various aspects of bacterial communities, from how the individuals in biofilms communicate, interact and evolve, to how they can used for the benefit of mankind and how they can make us ill.
-
Microbial evolution
November 2004
The November 2004 issue of Microbiology Today focuses on the evolution of microbes.
-
Microbial genomics
May 1998
The May 1998 issue of SGM Quarterly focuses on the current topic of microbial genomics.
-
Microbial phototrophs
August 2001
The August 2001 issue of Microbiology Today focuses on these highly photogenic organisms.
-
Microbial Tools
May 2018
The May 2018 issue of Microbiology Today focuses on the use of micro-organisms as tools in a wide range of contexts. Throughout our feature articles, there is an emphasis on the beneficial ways in which microbes can be utilised, in areas as diverse as construction, pest control and the disposal of radioactive waste.
-
Microbiology education
May 2001
The May 2001 issue of Microbiology Today focuses on the many facets of microbiology education.
-
Microbiology in food and drink
February 1997
The February 1997 issue of SGM Quarterly focuses on the use and effects of microbiology in food and drink.
-
Microbiology in Popular Culture
November 2017
Spanning television and film to books and video games, this issue of Microbiology Today features articles that examine and discuss how microbiology has been represented in popular culture.
-
Microbiology – the twilight zones
November 2000
The November 2000 issue of Microbiology Today focuses on questions such as how small IS the smallest unit of life? Is it really alive? And is it really a micro-organism?
-
Microbiology's Final Frontier
May 1997
The May 1997 issue of SGM Quarterly focuses on the exotic locations microbes have been found, and Cryptosporidium and E. coli, which have been hot topics recently.
-
Microeconomics
August 2011
The August 2011 issue of Microbiology Today is focused on the often overlooked impact microbes can have on economics.
-
Microscopy and Techniques
August 2006
The August 2006 issue of Microbiology Today focuses on the wonder that is microscopy.
-
Mind-altering microbes
February 2015
The February 2015 issue of Microbiology Today focuses on microbes that have mind-altering properties.
-
Mycobacteria
August 2014
The August 2014 issue of Microbiology Today focuses on a family of bacteria called mycobacteria.
-
Natural Products and Drug Discovery
November 2019
Natural Products and Drug Discovery are the topics explored in the November edition of Microbiology Today. Various potential sources of novel drugs are discussed, with the featured articles examining the promise of foods such as honey and garlic, as well as bacterial products. The repurposing of existing drugs is another topic covered in the featured articles, as well as the process of drug development from an industry perspective in the Comment piece.
-
Oceans
February 2019
The first 2019 issue of Microbiology Today explores microbes found throughout the world’s oceans. The five featured articles focus on a variety of micro-organisms, examining their wide-ranging roles within the marine environment and the impact they can have both in the sea and on dry land.
-
Pathogens
August 1999
The August 1999 issue of Microbiology Today focuses on the spread of pathogens.
-
Protists
October 2022
The October 2022 edition of Microbiology Today is titled 'Protists'. This issue highlights the importance of protistology research and engagement activities in collaboration with Protistology-UK.
-
Real superheroes
February 2014
The February 2014 issue of Microbiology Today features articles on microbial 'superheroes'.
-
Resistance to antimicrobials
August 1998
-
SARS-CoV-2 and COVID-19
October 2021
The October edition of Microbiology Today is titled 'SARS-CoV-2 and COVID-19'. This issue is dedicated to showcasing microbiologists' collaborative efforts to build our understanding of SARS-CoV-2, since its emergence, to improve COVID-19 management and prevention.
-
Sexually transmitted infections (STIs)
May 2013
This issue is primarily focused on sexually transmitted infections (STIs) and their impact.
-
Silicon
August 1997
The August 1997 issue of SGM Quarterly focuses on the microbiology of silicon and new technology.
-
Soil
May 2015
Welcome to the May 2015 issue of Microbiology Today, which focuses on soil microbiology.
-
Systematics
November 2006
The November 2006 issue of Microbiology Today focuses on the classification and definitions of microbes.
-
Systems and mathematics
February 2010
The February 2010 issue of Microbiology Today focuses on microbes used in and explained by systems and mathematics.
-
The future of microbiology
February 2000
The February 2000 issue of Microbiology Today focuses on the future of microbiology as we move into the new millennium.
-
The Ins and Outs of the Cell
May 2011
The May 2011 issue of Microbiology Today focuses on the ins and outs of the cell.
-
The Legacy of Fleming
February 2009
The February 2009 issue of Microbiology Today focuses on Alexander Fleming and the contributions he has made to the microbiology community.
-
The Microbiome
May 2017
Microbiome research is a hot topic at the moment, and this timely May 2017 issue of Microbiology Today focuses on how microbiomes influence human health as well as the wider world around us.
-
The Mobile Microbe
November 2016
The November 2016 issue of Microbiology Today is an extended special issue with the Australian Society for Microbiology's publication, Microbiology Australia. This edition focuses on travel and microbiology.
-
The neonate and early childhood
February 2012
This February 2012 issue of Microbiology Today looks at the positive and negative effects of bacteria and viruses on the human body at one of the most vulnerable times of our life.
-
The Ocean
May 2010
The May 2010 issue of Microbiology Today focuses on microbes that exist in oceans.
-
Vaccines
February 2006
The February 2006 issue of Microbiology Today focuses on the benefits of immunisation and the difficulties in creating new vaccines.
-
Viruses and Cancer - 2013
February 2013
This ‘virology special’ issue of Microbiology Today features articles on viruses and cancer.
-
Water
November 2014
The November 2014 issue of Microbiology Today focuses on microbial interactions with water.
-
What is life?
May 2016
The May 2016 issue of Microbiology Today tackles the question 'What is life?', looking at and exploring the different aspects related to it and the field of microbiology.
-
Why Microbiology Matters
May 2020
The theme of this special anniversary edition of Microbiology Today is ‘Why Microbiology Matters’, and it includes seven sections containing articles that provide examples of the many ways microbiology is important to our lives and the world around us.
-
Wildlife disease
November 2003
The November 2003 issue of Microbiology Today focuses on emerging infection diseases of wildlife. Some of these pathogens affect a wide range of animals, including domestic species and humans, whereas others are confined to their wildlife host and can devastate populations.
-
World War I
May 2014
The May 2014 issue of Microbiology Today marks the 100-year anniversary of the start of the First World War.
-
Zoonotic diseases
November 2015
Welcome to the November 2015 issue of Microbiology Today, which focuses on the diseases that can pass between animals and humans.